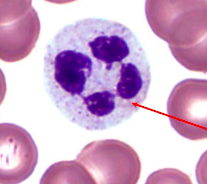
<p>type of white blood cell that engulfs bacteria</p>
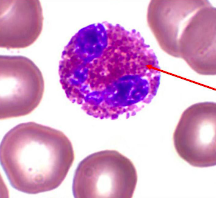
<p>type of white blood cell that fights infection</p>
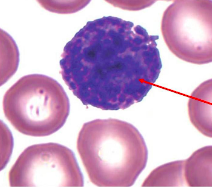
<p>type of white blood cell that releases heparin & histamine</p>
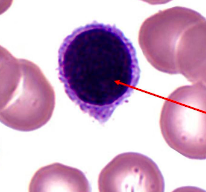
<p>type of white blood cell that fights infection</p>
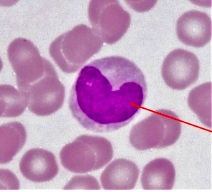
<p>type of white blood cell that transforms into macrophages and engulfs bacteria</p>
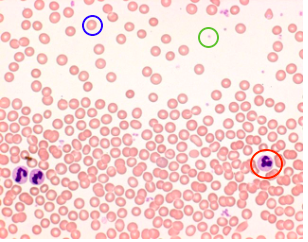
<p>What type of blood cell indicated by the green circle?</p>

A&P 150 Heart & Blood Lab 10
1/46
There's no tags or description
Looks like no tags are added yet.
Name | Mastery | Learn | Test | Matching | Spaced |
|---|
No study sessions yet.
47 Terms
aorta
Label 12

superior vena cava
Label 16

left coronary artery
Label 29

cardiac vein
Label 28

inferior vena cava
Label 26

coronary sinus
Label 27

pectinate muscle
Label 52

fossa ovalis
Label 55

inferior vena cava
What structure does opening 33 lead to?

coronary sinus
What structure does opening 58 lead to?

SA node
Label 32

AV node
Label 36

right AV valve
Label valve present at opening 5

pulmonary semilunar valve
Label valve present at opening 10

left AV valve
Label valve present at opening 41

chordae tendineae
Label branching structures 3

papillary muscle
Label red structure 62

aortic semilunar valve
Label the valve at opening 45

trabecular carnae
Label 1

interventricular septum
Label 5

left bundle branch
Label 43

left purkinje fiber
Label 2

neutrophil
type of white blood cell that engulfs bacteria
eosinophil
type of white blood cell that fights infection
basophil
type of white blood cell that releases heparin & histamine
lymphocyte
type of white blood cell that fights infection
monocyte
type of white blood cell that transforms into macrophages and engulfs bacteria
red
What type of blood cell indicated by the blue circle?

platelet
What type of blood cell indicated by the green circle?
white
What type of blood cell indicated by the red circle?

neutrophil, lymphocyte, monocyte, eosinophil, basophil
List the five white blood cells in order of abundance in the body
right atrium
Label chamber A

right ventricle
Label chamber B

left atrium
Label chamber C

left ventricle
Label chamber D

superior vena cava
Label 1

left pulmonary artery
Label 2

left pulmonary vein
Label 3

left AV valve
Label valve 4

aortic semilunar valve
Label valve 5

pulmonary trunk
Label 6

right pulmonary artery
Label 7

right pulmonary vein
Label 8

pulmonary semilunar valve
Label valve 9

right AV valve
Label valve 10

inferior vena cava
Label 11

aorta
Label 12
